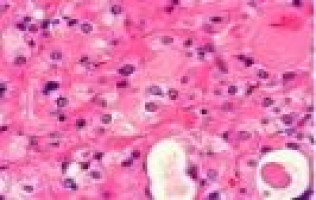
Particle accelerator waste could help produce cancer-fighting materials, study suggests

Energy that would normally go to waste inside powerful particle accelerators could be used to create valuable medical isotopes, scientists have found.
Researchers at the University of York have shown that intense radiation captured in particle accelerator “beam dumps” could be repurposed to produce materials used in cancer therapy.
Scientists have now found a way to make those leftover photons do a second job, without affecting the main physics experiments.
A beam of photons designed to investigate things like the matter that makes up our universe, could at the same time, be used to create useful medical isotopes in the diagnosis and treatment of cancer.
Dr Mamad Eslami, a nuclear physicist from the University of York’s Department of Physics, said: ”We have shown the potential to generate copper-67, a rare isotope used in both diagnosing and treating cancers, by demonstrating that what we might view as waste from a particle accelerator experiment into something that can save lives.
“Our method lets high-energy accelerators support cancer medicine while continuing their core scientific work.”
Copper-67 emits radiation that both destroys cancer cells and enables doctors to monitor treatment progress.
Clinical trials are already exploring its use against conditions such as prostate cancer and neuroblastoma, but global supplies remain limited due to production challenges.
Because large research particle accelerators often run for long periods, the process could build up useful amounts of isotopes gradually in parallel with other experiments, rather than requiring dedicated beam time.
This approach could allow existing physics facilities to double as sources of medical materials, helping in the creation of life-saving treatments whilst making better use of accelerator energy.
The next step for the team is to work with accelerator laboratories and medical partners to apply the method at other facilities and to explore how it could be scaled up to deliver clinically useful quantities of copper-67 and other useful isotopes in a reliable, cost-effective way.
The research is published in the journal, Physical Review C.
Article: Unconventional 67Cu production using high-energy bremsstrahlung and cross section evaluation
Source: University of York
We are an independent charity and are not backed by a large company or society. We raise every penny ourselves to improve the standards of cancer care through education. You can help us continue our work to address inequalities in cancer care by making a donation.
Any donation, however small, contributes directly towards the costs of creating and sharing free oncology education.
Together we can get better outcomes for patients by tackling global inequalities in access to the results of cancer research.
Thank you for your support.